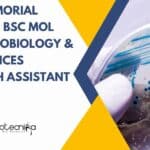
Tata Memorial Hospital BSc Mol Bio, Microbiology & Life Sciences Research Assistant Job Tata Memorial Hospital Jobs
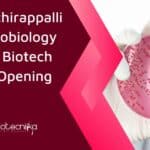
NIT Tiruchirappalli MSc Microbiology & MTech Biotech JRF Job Opening NIT Tiruchirappalli MSc Microbiology

Home Search
biology - search results
If you're not happy with the results, please do another search
ACG Universal Capsules Microbiology Job Opening For Candidates With 1-3 Years Exp, Apply Online
ACG Universal Capsules Microbiology Job Opening, Apply Online
ACG Universal Capsules Microbiology Job Opening, Apply Online. ACG Universal Capsules Careers. BSc Microbiology job openings. Quality...
ILS Genomic Surveillance Project Recruitment For MSc, PhD Life Sciences, Bioinformatics, Comp Biology
ILS Bioinformatics Project Job Opening For MSc, PhD
ILS Bioinformatics Project Job Opening For MSc, PhD. MSc, PhD Biotechnology, Life Sciences, Biochem, Bioinformatics, Microbiology, Comp...
Freshers MSc Microbiology Job at Takeda – Online Application Process
Freshers MSc Microbiology Job at Takeda - Online Application Process
Freshers MSc Microbiology Job at Takeda - Online Application Process. MSc Microbiology job opening. Officer...
IISER Tirupati MSc Biology JRF/PA Job Recruitment, Applications Invited
IISER Tirupati MSc Biology JRF/PA Job Recruitment, Applications Invited
IISER Tirupati MSc Biology JRF/PA Job Recruitment, Applications Invited. MSc SRF/PA Job. Project jobs at IISER...
Tata Memorial Hospital BSc Mol Bio, Microbiology & Life Sciences Research Assistant Job
Tata Memorial Hospital Jobs For BSc Mol Bio, Microbiology & Life Sciences
Tata Memorial Hospital Jobs For BSc Mol Bio, Microbiology & Life Sciences. BSc...
NIAB Walk-In-Interview For SRF/Project Associate Job For Biotech, Biochem, Microbiology & Immunology
NIAB Project Opening SRF/Project Associate For Biotech, Biochem
NIAB Project Opening SRF/Project Associate For Biotech, Biochem. National Institute of Animal Biotechnology vacancies. MSc Biochem, Microbiology,...
NIPER Hajipur JRF Job For MSc Biochem, Microbiology, Biotechnology
NIPER Hajipur JRF Job For MSc Biochem, Microbiology, Biotechnology
NIPER Hajipur JRF Job For MSc Biochem, Microbiology, Biotechnology. MSc Biochemistry/ Microbiology/ Biotechnology Junior Research Fellow...
CCMB Project Associate Job Openings – Mol Bio, Biochem, Cell Biology Apply
CCMB Project Associate Job Openings - Mol Bio, Biochem, Cell Biology Apply
CCMB Project Associate Job Openings - Mol Bio, Biochem, Cell Biology Apply. Project...
IIT Kharagpur MSc Biochem, Microbiology & Zoology Project Research Scientist Recruitment
IIT Kharagpur MSc Biochem, Microbiology & Zoology Project Research Scientist Recruitment
IIT Kharagpur MSc Biochem, Microbiology & Zoology Project Research Scientist Recruitment. MSc Biochem, Microbiology,...
RGCB Molecular Biology Project Assistant Recruitment, Apply Online
RGCB Molecular Biology Project Assistant Recruitment, Apply Online
RGCB Molecular Biology Project Assistant Recruitment, Apply Online. Rajiv Gandhi Centre for Biotechnology Job. Project Assistant RGCB...
BIRAC Jobs With Pay Ranging From Rs. 60,000 to Rs. 2 Lakh pm –...
BIRAC Jobs For Biotech, Biochem, Life, Biological Sciences, Microbiology Apply Online
BIRAC Jobs For Biotech, Biochem, Life, Biological Sciences, and Microbiology Apply Online. BIRAC Careers....
NIT Tiruchirappalli MSc Microbiology & MTech Biotech JRF Job Opening
NIT Tiruchirappalli MSc Microbiology & MTech Biotech JRF Job Opening
NIT Tiruchirappalli MSc Microbiology & MTech Biotech JRF Job Opening. NIT Tiruchirappalli Junior Research Fellow...
Want to be an Elephant Biologist? Then WWF Is Hiring – MSc Biology, Botany...
WWF India Job Openings For MSc Biology, Botany - Apply Online
WWF India Job Openings For MSc Biology, Botany - Apply Online. MSc Biology, Botany...
TIFR Hyderabad Job With Rs. 55,000 pm Pay For Biology, Life Sciences Graduates, Apply...
TIFR Hyderabad Job With Rs. 55,000 pm Pay For Biology, Life Sciences Graduates, Apply Online
TIFR Hyderabad Job With Rs. 55,000 pm Pay For Biology,...
NIMHANS Job For MSc Microbiology Candidates – Research Assistant Vacancy
NIMHANS Job For MSc Microbiology Candidates - Research Assistant Vacancy
NIMHANS Job For MSc Microbiology Candidates - Research Assistant Vacancy. MSc Microbiology vacancies. MSc job...